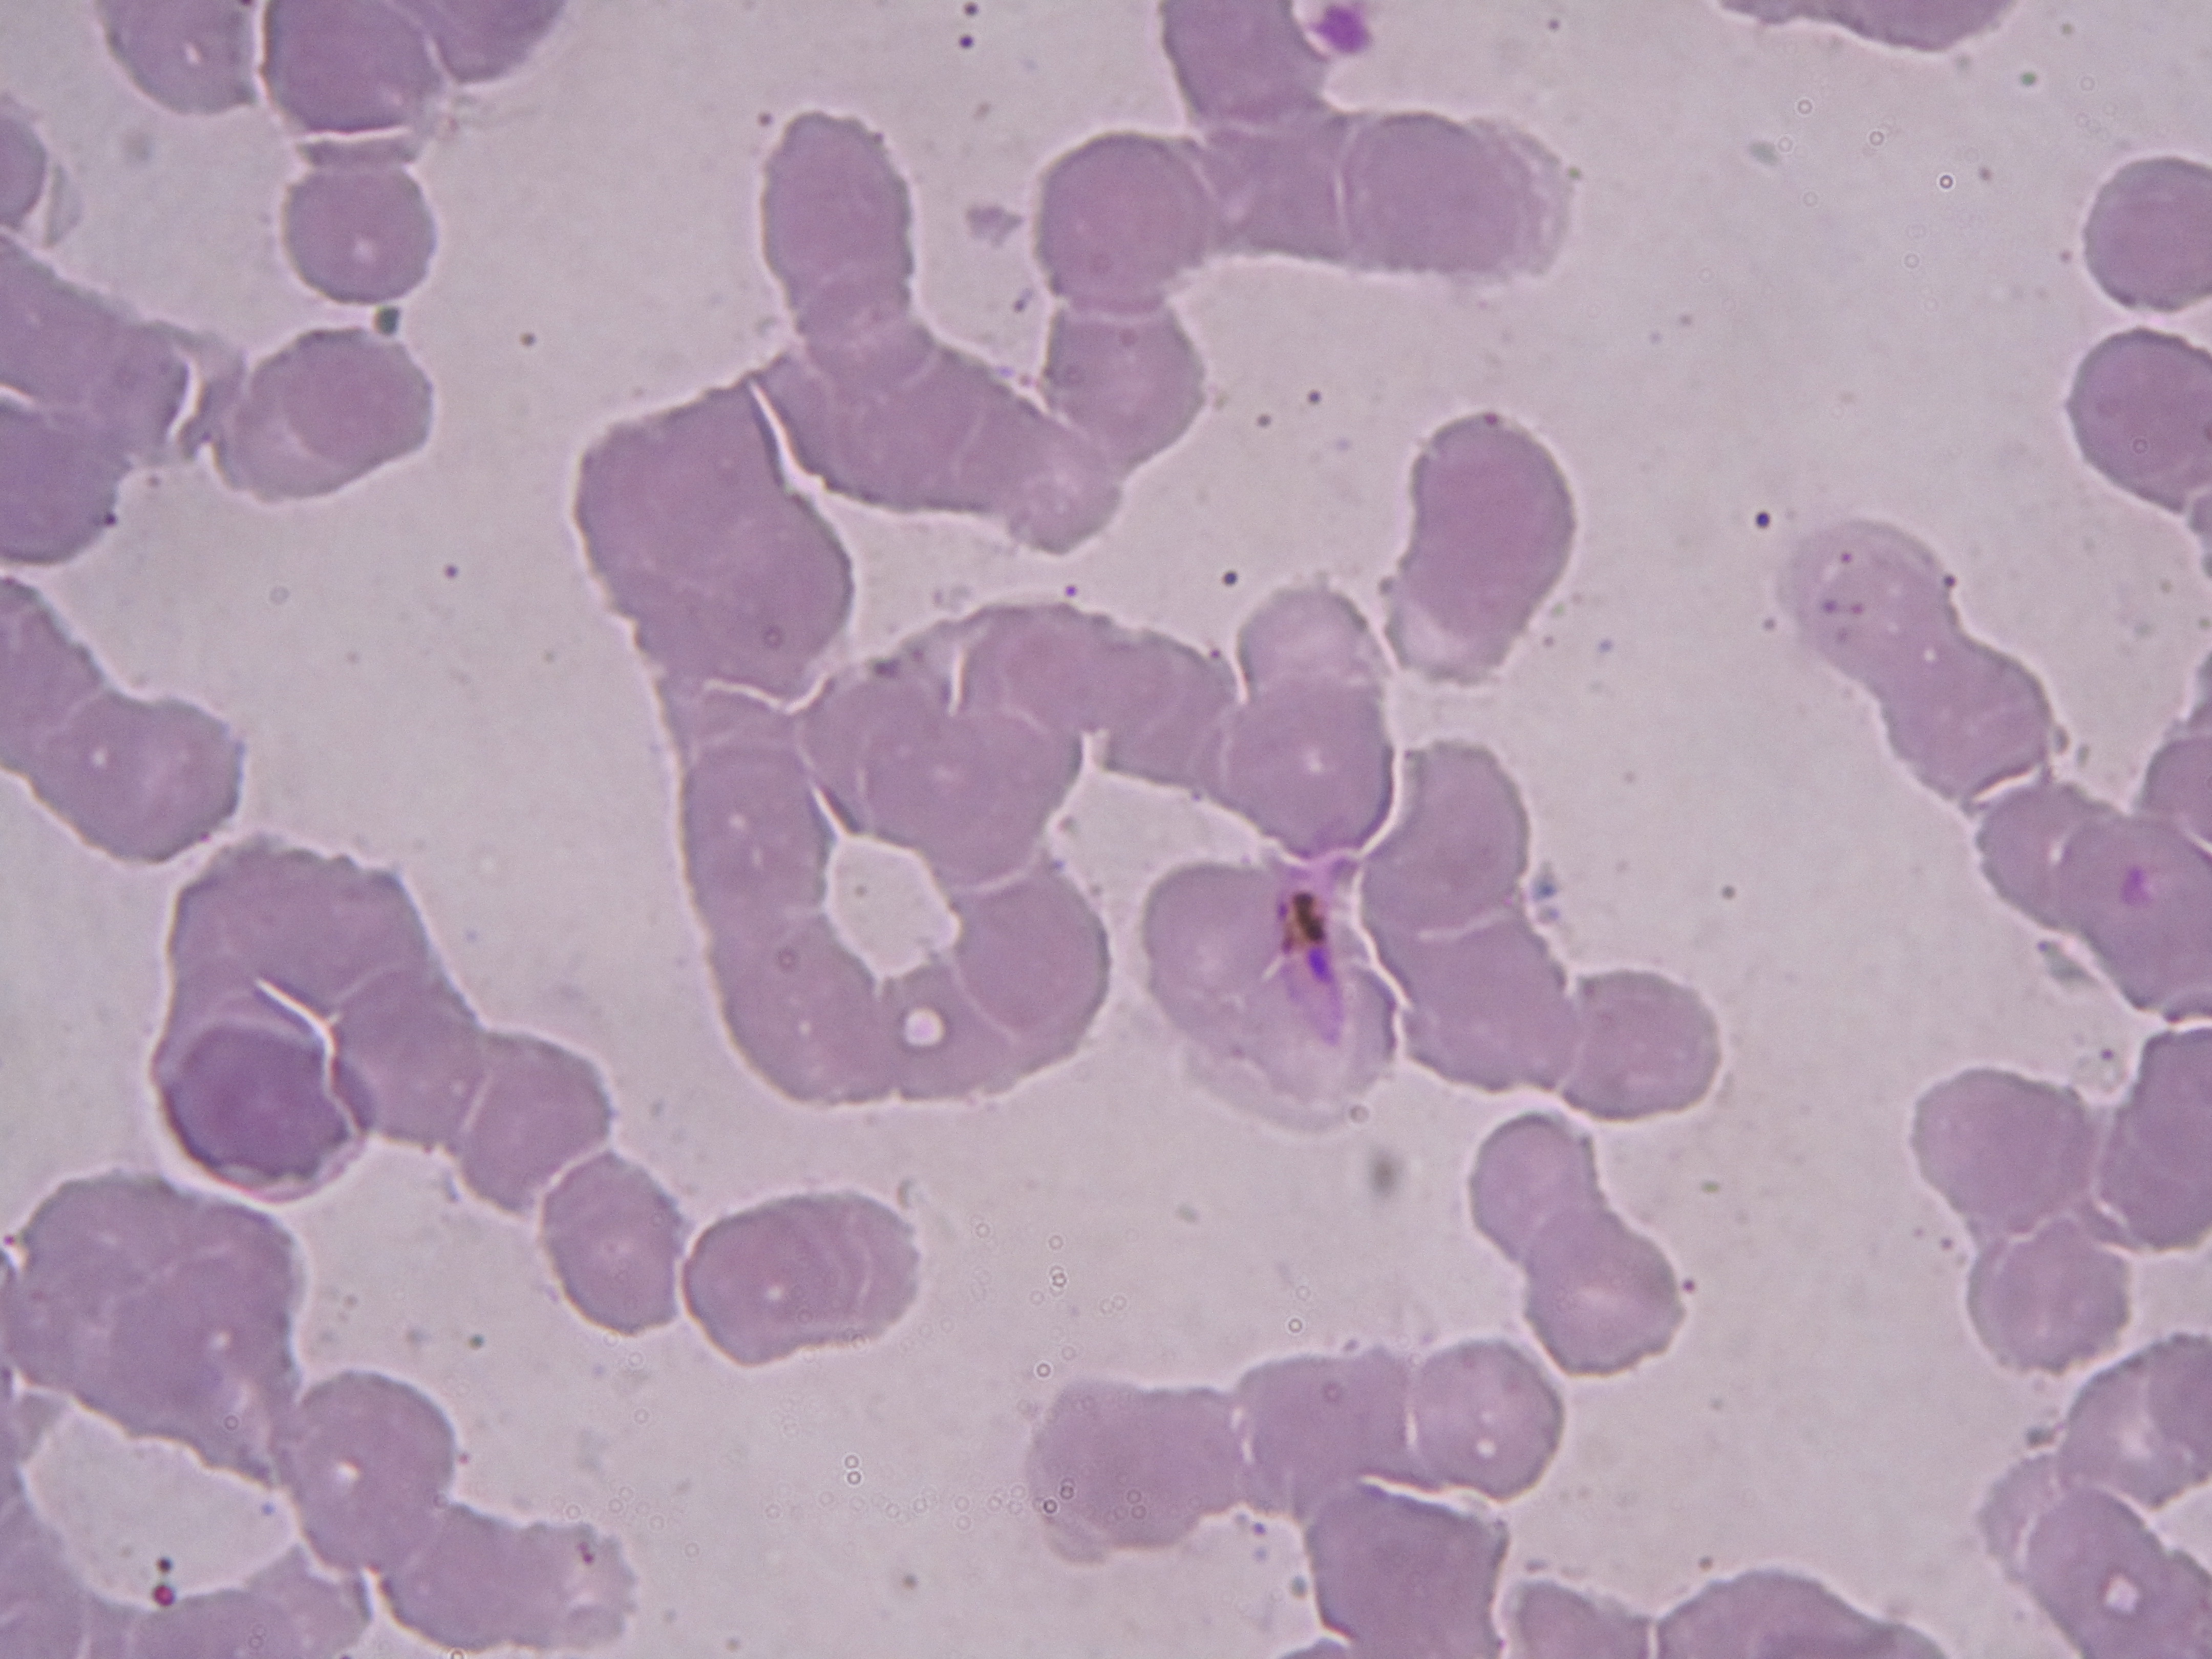

University of the Philippines, Diliman
Department of Computer Science
CS 180: Introduction to Artificial Intelligence
Applications of Artificial Intelligence
Applications of Artificial Intelligence
Search Engines

Applications of Artificial Intelligence
Automated driving
https://www.audi-mediacenter.com/en/press-releases/the-new-audi-a8-future-of-the-luxury-class-9124
Applications of Artificial Intelligence
Medical Imaging and Diagnosis

Applications of Artificial Intelligence
Marine Biomass Census


Applications of Artificial Intelligence
Speech Recognition



Applications of Artificial Intelligence
Language Translation

Facebook's Artificial Intelligence Robots Shut Down After They Start Talking to Each Other in Their Own Language
http://www.independent.co.uk/life-style/gadgets-and-tech/news/facebook-artificial-intelligence-ai-chatbot-new-language-research-openai-google-a7869706.html
http://www.independent.co.uk/life-style/gadgets-and-tech/news/facebook-artificial-intelligence-ai-chatbot-new-language-research-openai-google-a7869706.html
Other Applications of Artificial Intelligence
Robotics
Game Playing
Logistics Planning
Some applications of AI you will implement in this course
Path-findingDocument Classification
Spam Filtering
Emotion Detection on Voice
Facial and Pose Recognition